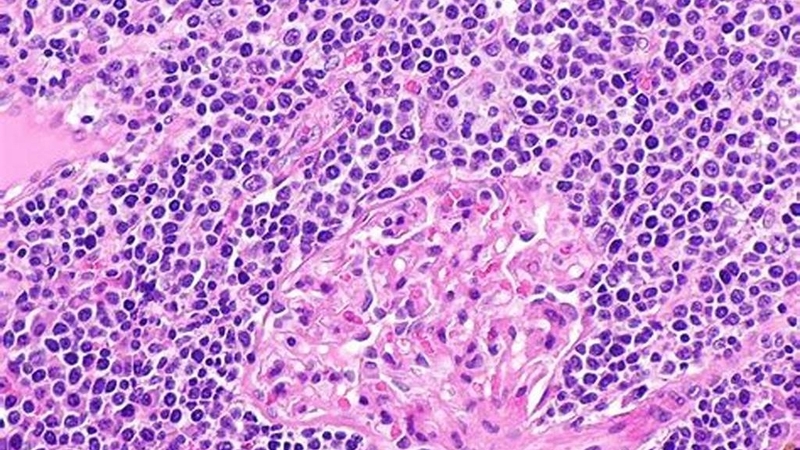
U lympho không Hodgkin tế bào B lớn tỏa rộng: Nguyên nhân, triệu chứng và điều trị 1

Từng làm ở Viện ISDS, nhiều năm cộng tác với CDC Thái Nguyên triển khai dự án phòng chống HIV/AIDS, 2 năm cộng tác với WHO.
Ánh Vũ
29/02/2024
Mặc định
Lớn hơn
Bạn có biết u lympho không Hodgkin tế bào B lớn tỏa rộng là gì không? Đây là một loại ung thư máu ác tính, bắt nguồn từ tế bào lympho B, một loại tế bào miễn dịch có nhiệm vụ sản xuất kháng thể. Bệnh có tốc độ phát triển nhanh và có thể gây ra nhiều triệu chứng khác nhau, tùy thuộc vào vị trí và mức độ lan rộng của khối u. Nếu không kịp thời được chẩn đoán và nhận phác đồ điều trị, tình trạng này có thể tiến triển nhanh chóng và cuối cùng dẫn đến tử vong. Vậy nguyên nhân, cách chẩn đoán và điều trị của bệnh là gì? Đọc bài viết dưới đây của Nhà thuốc Long Châu để hiểu rõ hơn về bệnh.
U lympho không Hodgkin tế bào B lớn tỏa rộng (DLBCL) là một loại ung thư máu ác tính phổ biến nhất trong nhóm bệnh U lympho không hodgkin. Bệnh có thể xuất hiện ở bất kỳ độ tuổi nào, nhưng thường gặp ở người lớn trung niên và cao tuổi. Bệnh có thể ảnh hưởng đến bất kỳ bộ phận nào trong cơ thể, nhưng thường gặp ở các hạch bạch huyết, tủy xương, lá lách, gan, phổi, da, tiêu hoá, não và tủy sống. Bài viết này sẽ cung cấp cho bạn những thông tin cần thiết về nguyên nhân, triệu chứng và điều trị của bệnh DLBCL.
Nguyên nhân gây ra u lympho không Hodgkin tế bào B lớn tỏa rộng (DLBCL) chưa được biết chắc chắn, nhưng có một số yếu tố có thể tăng nguy cơ mắc bệnh, bao gồm:
Triệu chứng của bệnh DLBCL có thể khác nhau tùy thuộc vào vị trí và kích thước của khối u. Một số triệu chứng thường gặp bao gồm:

U lympho không Hodgkin tế bào B lớn tỏa rộng là một trong những dạng ung thư hạch lympho phổ biến và nhanh chóng tiến triển, yêu cầu sự chẩn đoán chính xác và kịp thời để đảm bảo hiệu quả điều trị. Quá trình chẩn đoán bắt đầu với việc kiểm tra lâm sàng, bao gồm kiểm tra các hạch lympho bị sưng và thăm dò các triệu chứng khác như sốt, sụt cân không rõ nguyên nhân và mệt mỏi.
Xét nghiệm máu và các xét nghiệm hình ảnh như CT scan, PET scan được sử dụng để xác định vị trí và mức độ lan rộng của bệnh. Tuy nhiên, sinh thiết hạch lympho là bước quan trọng nhất, cho phép xác định chính xác loại tế bào lympho và mức độ ác tính của bệnh. Các bệnh nhân DLBCL được phân loại theo các giai đoạn từ I đến IV, tùy thuộc vào mức độ lan tỏa của bệnh.
Sau khi chẩn đoán chính xác, việc lựa chọn phương pháp điều trị bệnh u lympho không Hodgkin tế bào B lớn tỏa rộng phụ thuộc vào giai đoạn, loại và vị trí của khối u, cũng như tình trạng sức khỏe và tuổi tác của bệnh nhân.
Các liệu pháp thường áp dụng trong điều trị bao gồm:

Phòng ngừa và chăm sóc bệnh u lympho không Hodgkin tế bào B lớn tỏa rộng là những việc quan trọng để giảm nguy cơ mắc bệnh hoặc cải thiện tình trạng sức khỏe của bệnh nhân. Bạn có thể áp dụng các biện pháp sau đây:

Triển vọng và biến chứng của bệnh u lympho không Hodgkin tế bào B lớn tỏa rộng phụ thuộc vào nhiều yếu tố như giai đoạn, loại và vị trí của khối u, cũng như phản ứng của bệnh nhân với điều trị. Một số điểm cần lưu ý là:
Điều trị của bệnh DLBCL cũng có thể gây ra các tác dụng phụ như mất tóc, buồn nôn, nôn mửa, nhiễm trùng, thiếu máu, xuất huyết hoặc vô sinh.
U lympho không Hodgkin tế bào B lớn tỏa rộng là một loại ung thư máu nguy hiểm và phổ biến. Bệnh có thể gây ra nhiều triệu chứng khó chịu và ảnh hưởng đến chất lượng cuộc sống của bệnh nhân. Tuy nhiên, bệnh có thể được chẩn đoán và điều trị bằng nhiều phương pháp hiện đại và hiệu quả. Bệnh nhân nên thường xuyên khám sức khỏe, theo dõi các triệu chứng bất thường và tuân thủ đúng chỉ định của bác sĩ để có kết quả điều trị tốt nhất.
Dược sĩ Đại học Nguyễn Tuấn Trịnh
Từng làm ở Viện ISDS, nhiều năm cộng tác với CDC Thái Nguyên triển khai dự án phòng chống HIV/AIDS, 2 năm cộng tác với WHO.